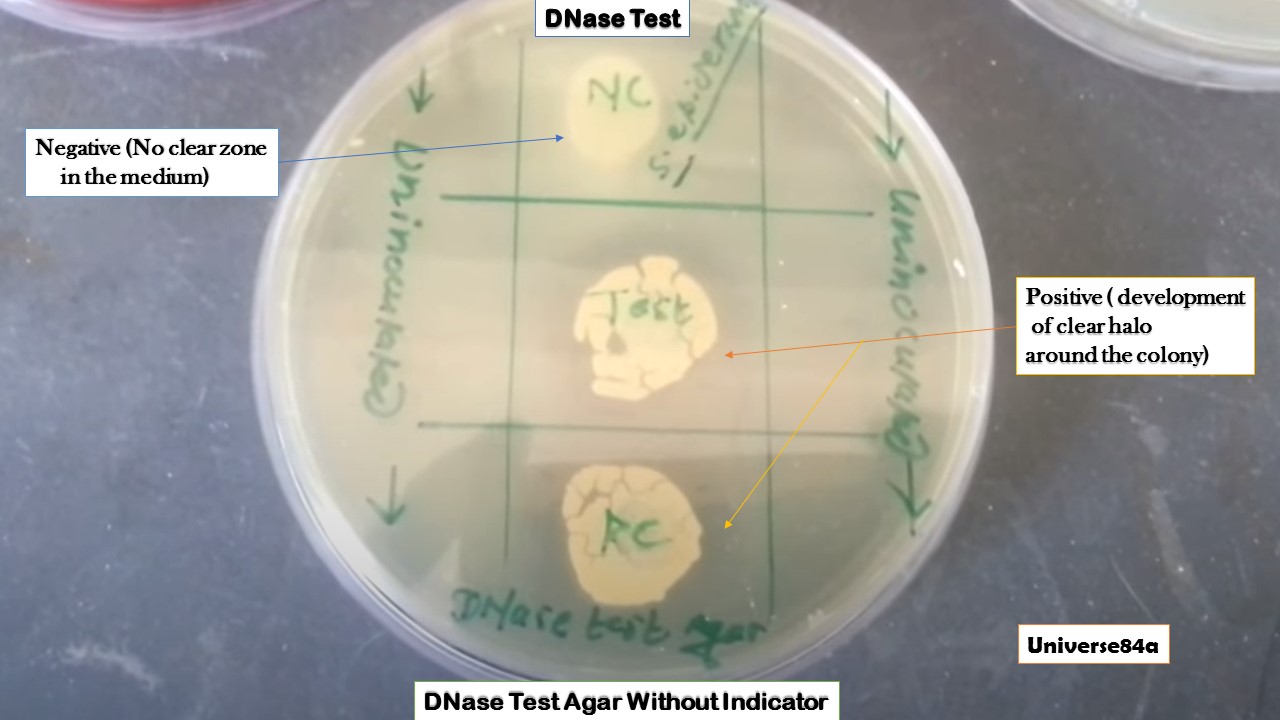

آزمایش DNase: راهنمای جامع و آموزشی برای تست DNase
خلاصه آزمایش DNase: روش کار تست deoxyribonuclease
آزمایش DNase یک تست بیوشیمیایی برای شناسایی باکتریها بر اساس تولید آنزیم DNase است که DNA را تجزیه میکند. روش کار: محیط DNase agar را با باکتری تلقیح کنید، ۲۴ ساعت در ۳۷°C انکوبه نمایید، سپس با HCl یا نشانگرهای رنگی مانند تولوئیدین بلو بررسی کنید. نتیجه مثبت: منطقه شفاف یا تغییر رنگ اطراف کلونی، نشاندهنده تجزیه DNA.
جهت عضویت در کانال آموزشی در تلگرام به لینک زیر مراجعه کنید:
https://t.me/hematology_education
فهرست مطالب آزمایش DNase
- مقدمه و تاریخچه آزمایش DNase
- اصل علمی آزمایش DNase و تست deoxyribonuclease
- مواد و تجهیزات مورد نیاز برای انجام آزمایش DNase
- روش انجام آزمایش DNase (گام به گام تست DNase)
- تفسیر نتایج آزمایش DNase و تست deoxyribonuclease
- کاربردها در میکروبیولوژی و پزشکی آزمایش DNase
- کنترل کیفیت در آزمایش DNase
- محدودیتها و خطاهای احتمالی در تست DNase
- نتیجهگیری آزمایش DNase
مقدمه و تاریخچه
آزمایش DNase (Deoxyribonuclease) یکی از تستهای بیوشیمیایی کلیدی در میکروبیولوژی است که برای شناسایی باکتریها بر اساس توانایی تولید آنزیم DNase استفاده میشود. این آنزیم، DNA را به نوکلئوتیدهای کوچکتر تجزیه میکند تا باکتری بتواند از آن به عنوان منبع کربن، نیتروژن و فسفر برای رشد استفاده کند. این تست اولین بار در سال 1957 توسط Jeffries و همکارانش توسعه یافت و به عنوان یک روش ساده برای تمایز گونههای باکتریایی معرفی شد. از آن زمان، این آزمایش در آزمایشگاههای بالینی و تحقیقاتی برای شناسایی پاتوژنهایی مانند Staphylococcus aureus کاربرد وسیعی یافته است. اهمیت آن در تشخیص سریع عفونتهای استافیلوکوکی، به ویژه در موارد مقاوم به آنتیبیوتیک، برجسته است.
این مقاله آموزشی به طور جامع به بررسی اصل علمی، مواد مورد نیاز، روشهای انجام، تفسیر نتایج، کاربردها، کنترل کیفیت و محدودیتهای این آزمایش میپردازد تا دانشجویان، تکنسینهای آزمایشگاه و محققان بتوانند آن را به طور دقیق اجرا و تفسیر کنند.
اصل علمی آزمایش DNase
اصل آزمایش DNase بر پایه فعالیت آنزیم deoxyribonuclease (DNase) استوار است. DNase یک اندونوکلئاز خارج سلولی است که پیوندهای فسفودیاستر در DNA را هیدرولیز میکند و آن را به الیگونوکلئوتیدها و نوکلئوتیدهای آزاد تبدیل مینماید. در محیط کشت DNase agar که حاوی DNA است، باکتریهای تولیدکننده DNase باعث تجزیه DNA میشوند. این تجزیه منجر به تشکیل یک منطقه شفاف (halo) اطراف کلونی باکتری میگردد، زیرا DNA تجزیهنشده با HCl رسوب میکند و کدر میشود، اما نواحی تجزیهشده شفاف باقی میمانند.
دو روش اصلی برای تشخیص وجود دارد:
1. روش با HCl: پس از انکوباسیون، HCl 1N اضافه میشود تا DNA باقیمانده رسوب کند.
2. روش با نشانگرهای رنگی: مانند متیل گرین (که در حضور DNA کمپلکس سبز تشکیل میدهد و با تجزیه به بیرنگ تبدیل میشود) یا تولوئیدین بلو (که در نواحی مثبت به رنگ صورتی درمیآید). این روشها به دلیل سادگی و هزینه کم، در آزمایشگاههای روتین ترجیح داده میشوند.
مواد و تجهیزات مورد نیاز برای آزمایش DNase
برای انجام آزمایش DNase، مواد زیر ضروری است:
– محیط کشت DNase agar: شامل تریپتون (15 گرم)، پپتون سویا (5 گرم)، DNA (2 گرم)، NaCl (5 گرم)، آگار (15 گرم) در 1 لیتر آب مقطر. pH محیط باید 7.3 باشد. میتوان نشانگرهایی مانند تولوئیدین بلو (0.1 گرم) یا متیل گرین (0.05 گرم) اضافه کرد.
– معرفها: HCl 1N برای روش بدون نشانگر.
– ابزارها: لوپ استریل، انکوباتور در 37°C، پتری دیش، لولههای آزمایش برای کشت اولیه.
– کنترلها: باکتری کنترل مثبت (مانند Serratia marcescens یا Staphylococcus aureus) و کنترل منفی (مانند Staphylococcus epidermidis).
محیط را باید در اتوکلاو استریل کرد (121°C به مدت 15 دقیقه) و در پتری دیش ریخت. اگر نشانگر اضافه شود، محیط را پس از اتوکلاو خنک کنید و سپس نشانگر را بیفزایید تا از تخریب آن جلوگیری شود.
روش انجام آزمایش DNase (گام به گام تست deoxyribonuclease)
آزمایش DNase را میتوان به دو روش اصلی انجام داد. در ادامه، پروتکل دقیق هر کدام توضیح داده شده است:
روش 1: با HCl (روش کلاسیک آزمایش DNase)
1. آمادهسازی محیط: محیط DNase agar را تهیه و استریل کنید. آن را در پتری دیش بریزید و اجازه دهید سفت شود.
2. تلقیح نمونه: باکتری مورد آزمایش را از کشت تازه (18-24 ساعته) بردارید و به صورت نقطهای (spot) یا خطی (streak) روی محیط تلقیح کنید. از inoculum سنگین اجتناب کنید تا نتایج کاذب جلوگیری شود.
3. انکوباسیون: پتری دیش را به مدت 18-24 ساعت (یا تا 48 ساعت برای برخی گونهها) در 37°C انکوبه کنید.
4. اضافه کردن معرف: پس از انکوباسیون، HCl 1N را روی سطح محیط بریزید تا کل صفحه پوشش داده شود.
5. مشاهده: بلافاصله نتایج را بررسی کنید. منطقه شفاف اطراف کلونی نشاندهنده مثبت بودن است، زیرا DNA تجزیه شده و رسوب نمیکند.
روش 2: با نشانگر تولوئیدین بلو یا متیل گرین در تست DNase
1. آمادهسازی محیط: نشانگر را به محیط اضافه کنید (تولوئیدین بلو: آبی، متیل گرین: سبز).
2. تلقیح و انکوباسیون: همانند روش قبل.
3. مشاهده بدون معرف اضافی: پس از انکوباسیون، تغییر رنگ را بررسی کنید:
– تولوئیدین بلو: منطقه صورتی اطراف کلونی مثبت است (به دلیل آزاد شدن نوکلئوتیدها).
– متیل گرین: منطقه بیرنگ مثبت است (کمپلکس سبز تجزیه میشود).
این روش ایمنتر است زیرا HCl باکتریکش نیست و اجازه میدهد کلونیها برای آزمایشهای بعدی برداشته شوند.
نکته آموزشی: همیشه از دستکش و عینک ایمنی استفاده کنید، به ویژه هنگام کار با HCl. همچنین، از تلقیح بیش از حد اجتناب کنید زیرا ممکن است منجر به decolorization کاذب شود.
تفسیر نتایج آزمایش DNase
– نتیجه مثبت: تشکیل منطقه شفاف (با HCl) با قطر حداقل 2-3 میلیمتر، یا تغییر رنگ (صورتی با تولوئیدین بلو، بیرنگ با متیل گرین). مثال: Staphylococcus aureus (منطقه شفاف گسترده)، Serratia marcescens (مثبت قوی).
– نتیجه منفی: عدم تشکیل منطقه شفاف یا تغییر رنگ. مثال: Staphylococcus epidermidis، Escherichia coli.
– نتایج مبهم: اگر منطقه کوچک باشد، آزمایش را تکرار کنید یا از روشهای مولکولی استفاده نمایید.
جدول تفسیر نتایج نمونه:
| باکتری | نتیجه DNase | توضیحات |
|---|---|---|
| S. aureus | مثبت | منطقه شفاف گسترده |
| S. epidermidis | منفی | بدون تغییر |
| S. marcescens | مثبت | تغییر رنگ صورتی |
| Moraxella catarrhalis | مثبت | مفید برای تمایز از نایسریا |
کاربردها در میکروبیولوژی و پزشکی
آزمایش DNase کاربردهای متنوعی دارد:
– تمایز استافیلوکوکها: برای جداسازی S. aureus (مثبت) از کواگولاز منفی مانند S. epidermidis (منفی). این در تشخیص عفونتهای پوستی، سپتیسمی و اندوکاردیت حیاتی است.
– شناسایی Serratia و Moraxella: Serratia marcescens اغلب مثبت است و در عفونتهای بیمارستانی نقش دارد. Moraxella catarrhalis مثبت است و از Neisseria تمایز مییابد.
– کاربردهای تحقیقاتی: مطالعه بیان ژن DNase در باکتریهای مقاوم به آنتیبیوتیک مانند MRSA.
– تشخیص بالینی: در ترکیب با تستهای دیگر مانند کواگولاز، برای تایید پاتوژنها در نمونههای بالینی مانند خون، ادرار یا زخم.
کنترل کیفی آزمایش DNase
کنترل کیفی زمایش DNase جهت اطمینان از دقت و صخت آزمایش انجام می شود و به شرح زیر است:
– کنترل مثبت: S. aureus یا S. marcescens – باید منطقه شفاف نشان دهد.
– کنترل منفی: S. epidermidis – بدون تغییر.
– کنترل محیط: بررسی استریلیتی محیط قبل از استفاده.
– استانداردها: طبق UK Standards for Microbiology Investigations، آزمایش را با کنترلهای استاندارد انجام دهید.
جهت مطالعه جامع در مورد کنترل کیفی میکروب شناسی به لینک زیر مراجعه کنید:
کنترل کیفی میکروب شناسی: اصول، روشها و استانداردهای عملکردی
محدودیتها و خطاهای احتمالی
علیرغم سادگی، محدودیتهایی وجود دارد:
– نتایج کاذب: inoculum بزرگ ممکن است رسانه را کاملاً decolorize کند. برخی سویههای MRSA DNase ضعیف تولید میکنند و منفی کاذب میدهند.
– باکتریکشی HCl: در روش HCl، نمیتوان کلونیها را برای آزمایشهای بعدی استفاده کرد، زیرا HCl باکتریها را میکشد.
– عدم اختصاصیت: برخی گونههای غیرپاتوژن مانند Bacillus نیز مثبت هستند.
– زمانبر بودن: برای برخی باکتریها نیاز به انکوباسیون طولانیتر (تا 72 ساعت) دارد.
– راهحلها: از روشهای نشانگر استفاده کنید و همیشه با تستهای دیگر مانند PCR ترکیب نمایید.
نتیجهگیری
آزمایش DNase یک ابزار آموزشی و عملی ارزشمند در میکروبیولوژی است که با درک اصل آن، میتوانید عفونتهای باکتریایی را سریعتر تشخیص دهید. با تمرین پروتکلهای فوق، دقت خود را افزایش دهید و محدودیتها را در نظر بگیرید. برای اطلاعات بیشتر، به منابع استاندارد مانند CDC یا NIH مراجعه کنید.
سوالات رایج
1. آزمایش DNase چیست؟
آزمایش DNase تستی برای شناسایی باکتریهای تولیدکننده آنزیم DNase است که DNA را تجزیه میکند.
2. اصل علمی آزمایش DNase چگونه است؟
بر پایه هیدرولیز DNA توسط DNase و تشکیل منطقه شفاف یا تغییر رنگ در محیط کشت.
3. مواد مورد نیاز برای تست DNase چیست؟
محیط DNase agar، HCl، نشانگرها مانند تولوئیدین بلو، و ابزارهای آزمایشگاهی پایه.
4. روش انجام آزمایش DNase با HCl چگونه است؟
تلقیح باکتری، انکوباسیون ۲۴ ساعته، اضافه HCl و بررسی منطقه شفاف.
5. نتیجه مثبت در تست DNase به چه معناست؟
منطقه شفاف یا تغییر رنگ اطراف کلونی، نشاندهنده تولید DNase.
6. کدام باکتریها در آزمایش DNase مثبت هستند؟
مانند S. aureus، S. marcescens و Moraxella catarrhalis.
7. کاربردهای تست DNase در پزشکی چیست؟
تمایز استافیلوکوکها و شناسایی پاتوژنها در عفونتهای بالینی.
8. کنترل کیفیت در تست DNase چگونه انجام میشود؟
با استفاده از کنترل مثبت مانند S. aureus و منفی مانند S. epidermidis.
9. محدودیتهای آزمایش DNase چیست؟
نتایج کاذب، باکتریکشی HCl و عدم اختصاصیت برای برخی گونهها.
10. آیا آزمایش DNase برای تشخیص MRSA مفید است؟
بله، اما برخی سویههای MRSA ممکن است DNase ضعیف تولید کنند و نیاز به تستهای اضافی باشد.
11. تفاوت روش HCl و نشانگر در تست DNase چیست؟
روش HCl نیاز به معرف اضافی دارد و باکتریکش است، اما روش نشانگر ایمنتر و بدون نیاز به HCl.
12. زمان انکوباسیون در آزمایش DNase چقدر است؟
معمولاً ۱۸-۲۴ ساعت، اما تا ۴۸-۷۲ ساعت برای برخی گونهها.